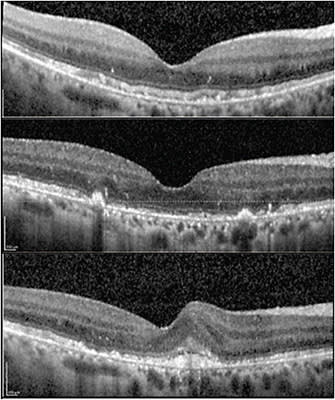
FIGURE 2: This image of the same patient shows the onset of choroidal neovascularization (CNV) in the contralateral eye. Over the course of 6 months the patient developed CNV and further vision loss. The top image was taken at first presentation, the second at 4 months following the onset of CNV, and the bottom image at 6 months following CNV onset. IMAGE COURTESY ZACK OAKEY, MD

Pentosan polysulfate sodium (PPS) is a medication that is approved by the US Food and Drug Administration for symptomatic pain relief associated with interstitial cystitis.1 It has been available in the United States for many off-label indications, such as treatment of varicose veins, and even recently as a treatment for osteoarthritis and other joint disorders in veterinary medicine.2,3 PPS is a sulfated polysaccharide that is structurally similar to heparin; it is thought to work by reducing inflammation in the urinary bladder by providing a protective coating against inflammatory cytokines.4 However, PPS has been associated with a rare but serious side effect known as pigmentary retinopathy.
Despite being in use since the 1950s, it was in 2018 that Pearce and colleagues described a unique pigmentary macular disorder in long-term users of the medication.5 In the original study, the authors identified 38 patients with pigmentary retinopathy who had taken the medication for a mean of 15.5 years and demonstrated no other identifiable explanation for the disease, including inherited retinal conditions such as Stargardt disease or cone-rod dystrophy. Patients in the Pearce study underwent examination, medical and family history interviews, next-generation macular dystrophy panel sequencing via EGL Genetics, and whole exome sequencing. None of these revealed a genetic explanation for their symptoms.
Pearce’s findings have subsequently been replicated in other studies. The unifying theme seems to include an initially mild paracentral hyper-pigmentation within the retinal pigment epithelium (RPE). Later, some develop an array of vitelliform-like deposits within the penumbra of central RPE hyperpigmentation. When followed over time, some patients developed sectoral, central/posterior—but also seemingly random—geographic atrophy and central vision loss.
The exact mechanism by which PPS causes pigmentary retinopathy has not yet been thoroughly described. Some researchers postulate that PPS may preferentially interact with metabolic proteins of pigmented cells in the retina, leading to their abnormal proliferation. This seems like a plausible explanation given that anomalous physiology has been demonstrated in an analogous manner in the uroepithelium for its other indications.6
CHARACTERISTICS
Pigmentary retinopathy can demonstrate several phenotypes. They include retinal pigment epithelium hypertrophy, geographic atrophy, and choroidal neovascularization (CNV).
Retinal pigment epithelium hypertrophy is characterized by an abnormal thickening of the RPE; it is most often seen on optical coherence tomography (OCT). Though not a direct insult to vision, RPE thickening may result from PPS’s effects on the choriocapillaris as its primary circulatory source—but there is uncertainty whether this is a secondary result of another primary pathophysiology that is identifiable with studies or is part of the primary disease process.7
As RPE becomes increasingly diseased, the overlying macular photoreceptors are unable to sustain normal homeostasis and function, resulting in atrophy. Both in the first Pearce report and others, macular degeneration–like geographic atrophy has been found (Figure 1).8

With inflammatory reactions to the above errors in metabolism, and changes in choriocapillaris architecture and physiology, it is thought that a reactive choroidal neovascularization can develop (Figure 2).9 Similar to other diagnoses, such as macular neovascularization in myopia and exudative age-related macular degeneration, substantial central vision loss can result.
DIAGNOSIS AND THERAPY
The diagnosis of PPS-associated pigmentary retinopathy is typically made based on the patient’s history, including of interstitial cystitis, and the findings of a thorough eye examination. This includes a dilated fundus examination and imaging studies such as OCT, fundus autofluorescence (FAF), and fluorescein angiography (FA) if choroidal neovascularization is suspected.
Treatment of PPS-associated pigmentary retinopathy is challenging and often unsatisfactory. The first step in therapy is eliminating pentosan polysulfate sodium and working with colleagues in urology to find a suitable alternative. If the condition is caught early, discontinuing PPS may prevent further progression of the disorder. Whether continued injury occurs in an analogous manner to hydroxychloroquine, or if recovery is possible after a period of abstinence, remains unknown. However, once retinal damage has occurred, the damage is likely irreversible. In cases where CNV is diagnosed, photodynamic therapy or injection with vascular endothelial growth factor inhibitors (anti-VEGF) may be used to reduce the retinal injury associated with choroidal neovascularization and slow the progression of the disorder. Nevertheless, treatment for CNV associated with PPS toxicity is considered off-label and it is unknown whether the condition should be approached aggressively, as in cases of exudative macular degeneration, or with prompt attempted cessation, as is more common in CNV cases associated with myopia.
CONCLUSION
Pentosan polysulfate sodium is a medication that is used to treat interstitial cystitis. However, PPS has been associated with a rare but potentially serious side effect known as pigmentary retinopathy. Though relatively new, a burgeoning literature is available to the retinal physician to understand the condition, make an appropriate diagnosis, and recommend treatment. NRP
REFERENCES
- Janssen Pharmaceuticals. Elmiron 100 mg (pentosan polysulfate sodium) capsules prescribing information. US Food and Drug Administration. June 2020. Accessed February 16, 2023. https://www.accessdata.fda.gov/drugsatfda_docs/label/2020/020193s014lbl.pdf
- Frileux C. Thrombocid: a new synthetic anticoagulant. Presse Med (1893). 1951;59(8):159.
- US Food and Drug Administration. FDA approves first injectable pentosan for osteoarthritis in horses. December 20, 2022. Accessed February 16, 2023. https://www.fda.gov/animal-veterinary/cvm-updates/fda-approves-first-injectable-pentosan-osteoarthritis-horses
- Parsons CL. The therapeutic role of sulfated polysaccharides in the urinary bladder. Urol Clin North Am. 1994;21(1):93-100.
- Pearce WA, Chen R, Jain N. Pigmentary maculopathy associated with chronic exposure to pentosan polysulfate sodium. Ophthalmology. 2018;125(11):1793-1802. doi:10.1016/j.ophtha.2018.04.026
- Pantazopoulos D, Karagiannakos P, Sofras F, Kostakopoulos A, Deliveliotis C, Dimopoulos C. Effect of drugs on crystal adhesion to injured urothelium. Urology. 1990;36(3):255-259. doi:10.1016/0090-4295(90)80268-r
- Fogel Levin M, Santina A, Corradetti G, et al. Pentosan polysulfate sodium–associated maculopathy: early detection using OCT angiography and choriocapillaris flow deficit analysis. Am J Ophthalmol. 2022;244:38-47. doi:10.1016/j.ajo.2022.07.015
- Shah R, Simonett JM, Lyons RJ, Rao RC, Pennesi ME, Jain N. Disease course in patients with pentosan polysulfate sodium–associated maculopathy after drug cessation. JAMA Ophthalmol. 2020;138(8):894-900. doi:10.1001/jamaophthalmol.2020.2349
- Mishra K, Patel TP, Singh MS. Choroidal neovascularization associated with pentosan polysulfate toxicity. Ophthalmol Retina. 2020;4(1):111-113. doi:10.1016/j.oret.2019.08.006








